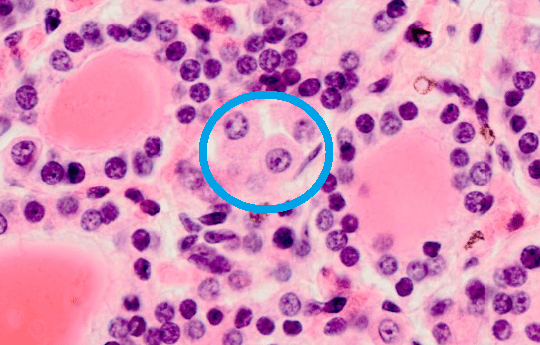

Dieser Bereich der Nervenzelle ist frei von rER.

Axonhügel
Diese Zellen bilden die Myelinscheide im PNS.
Schwann'sche Zellen
Dies ist die härteste Substanz des menschlichen Körpers.
Zahnschmelz
Diese Bindegewebsschicht wird im Wirbelsäulenbereich auch als äußeres Blatt der harten Rückenmarshaut bezeichnet.
Periost
Diese Färbung wird verwendet, um das raue endoplasmatische Retikulum in Neuronen anzufärben.
Nissl-Färbung
Beim quergestreiften Muskel trägt eine neuronale Synapse diesen speziellen Namen.

motorische Endplatte
Diese Bindegewebsschicht umgibt einzelne Nervenfaserbündel.
Perineurium
Diese 6 Hormone werden im Hypophysenvorderlappen gebildet.
FSH, LH, ACTH, TSH, Prolactin, GH
Zwischen den Fasern dieser Hautschicht befindet sich der cerebrospinale Liquor.
Arachnoidea mater
In dieser Färbung stellen sich Zellkerne und Zytoplasma rot dar. Bindegewebe ist blau.
Azan-Färbung
Im Vorderhorn des Rückenmarks finden sich diese Zellen.
Motoneurone
Neurone mit zentral liegendem Zellkern und deutlichem Nukleolus finden sich vor allem in dieser Art von Ganglion.
Spinalganglion / sensibles Ganglion
Diese Zellen steuern den Calcium-Spiegel des Blutes.
C-Zellen
So wird die Rückenmarkshaut genannt, die dem Rückenmark am nächsten liegt.
Pia mater spinalis
Diese metallbasierte Färbung erlaubt vor allem die Anfärbung von fettlöslichen Substanzen im Nervengewebe.
Markscheidenfärbung
So heißt der Bereich zwischen zwei myeliniserten Axonbereichen.
Ranvier'scher Schnürring
In dieser Ganglion-Art finden sich Neurone mit peripher gelegenem Zellkern.
autonomes Ganglion
Diese Fasern verankern den Zahnkörper im Alveolarknochen.
Sharpey-Fasern
Die Dura mater wird auch mit diesem Namen bezeichnet. Er leitet sich vom griechischen Wort für "derb" und "Haut" ab.
Pachymeninx
In dieser Darstellung stellt sich die Myelinscheide ähnlich einer Lakritzschnecke dar.
Elektronenmikroskopie
So breit kann der synaptische Spalt sein.
10 bis 50 nm
Diese Zellen gehören zu den Neurogliazellen und finden sich in Ganglien.
Mantelzellen, Satellitenzellen
Diese Hormongruppe wird in der Zona reticularis gebildet.
Androgene
Zur selektiven Betäubung von Spinalnerven wird diese Art der Lokalanästhesie verwendet. Sie findet häufig Verwendung zur Linderung von Wehenschmerz.
Epiduralanästhesie
Die selektive Anfärbung von Neuronen mit ihren Fortsätzen gelingt mit dieser - nach einem italienischen Anatomen benannte - Färbung. Die gefärbten Strukturen werden als "argyrophil" bezeichnet.
Golgi-Färbung